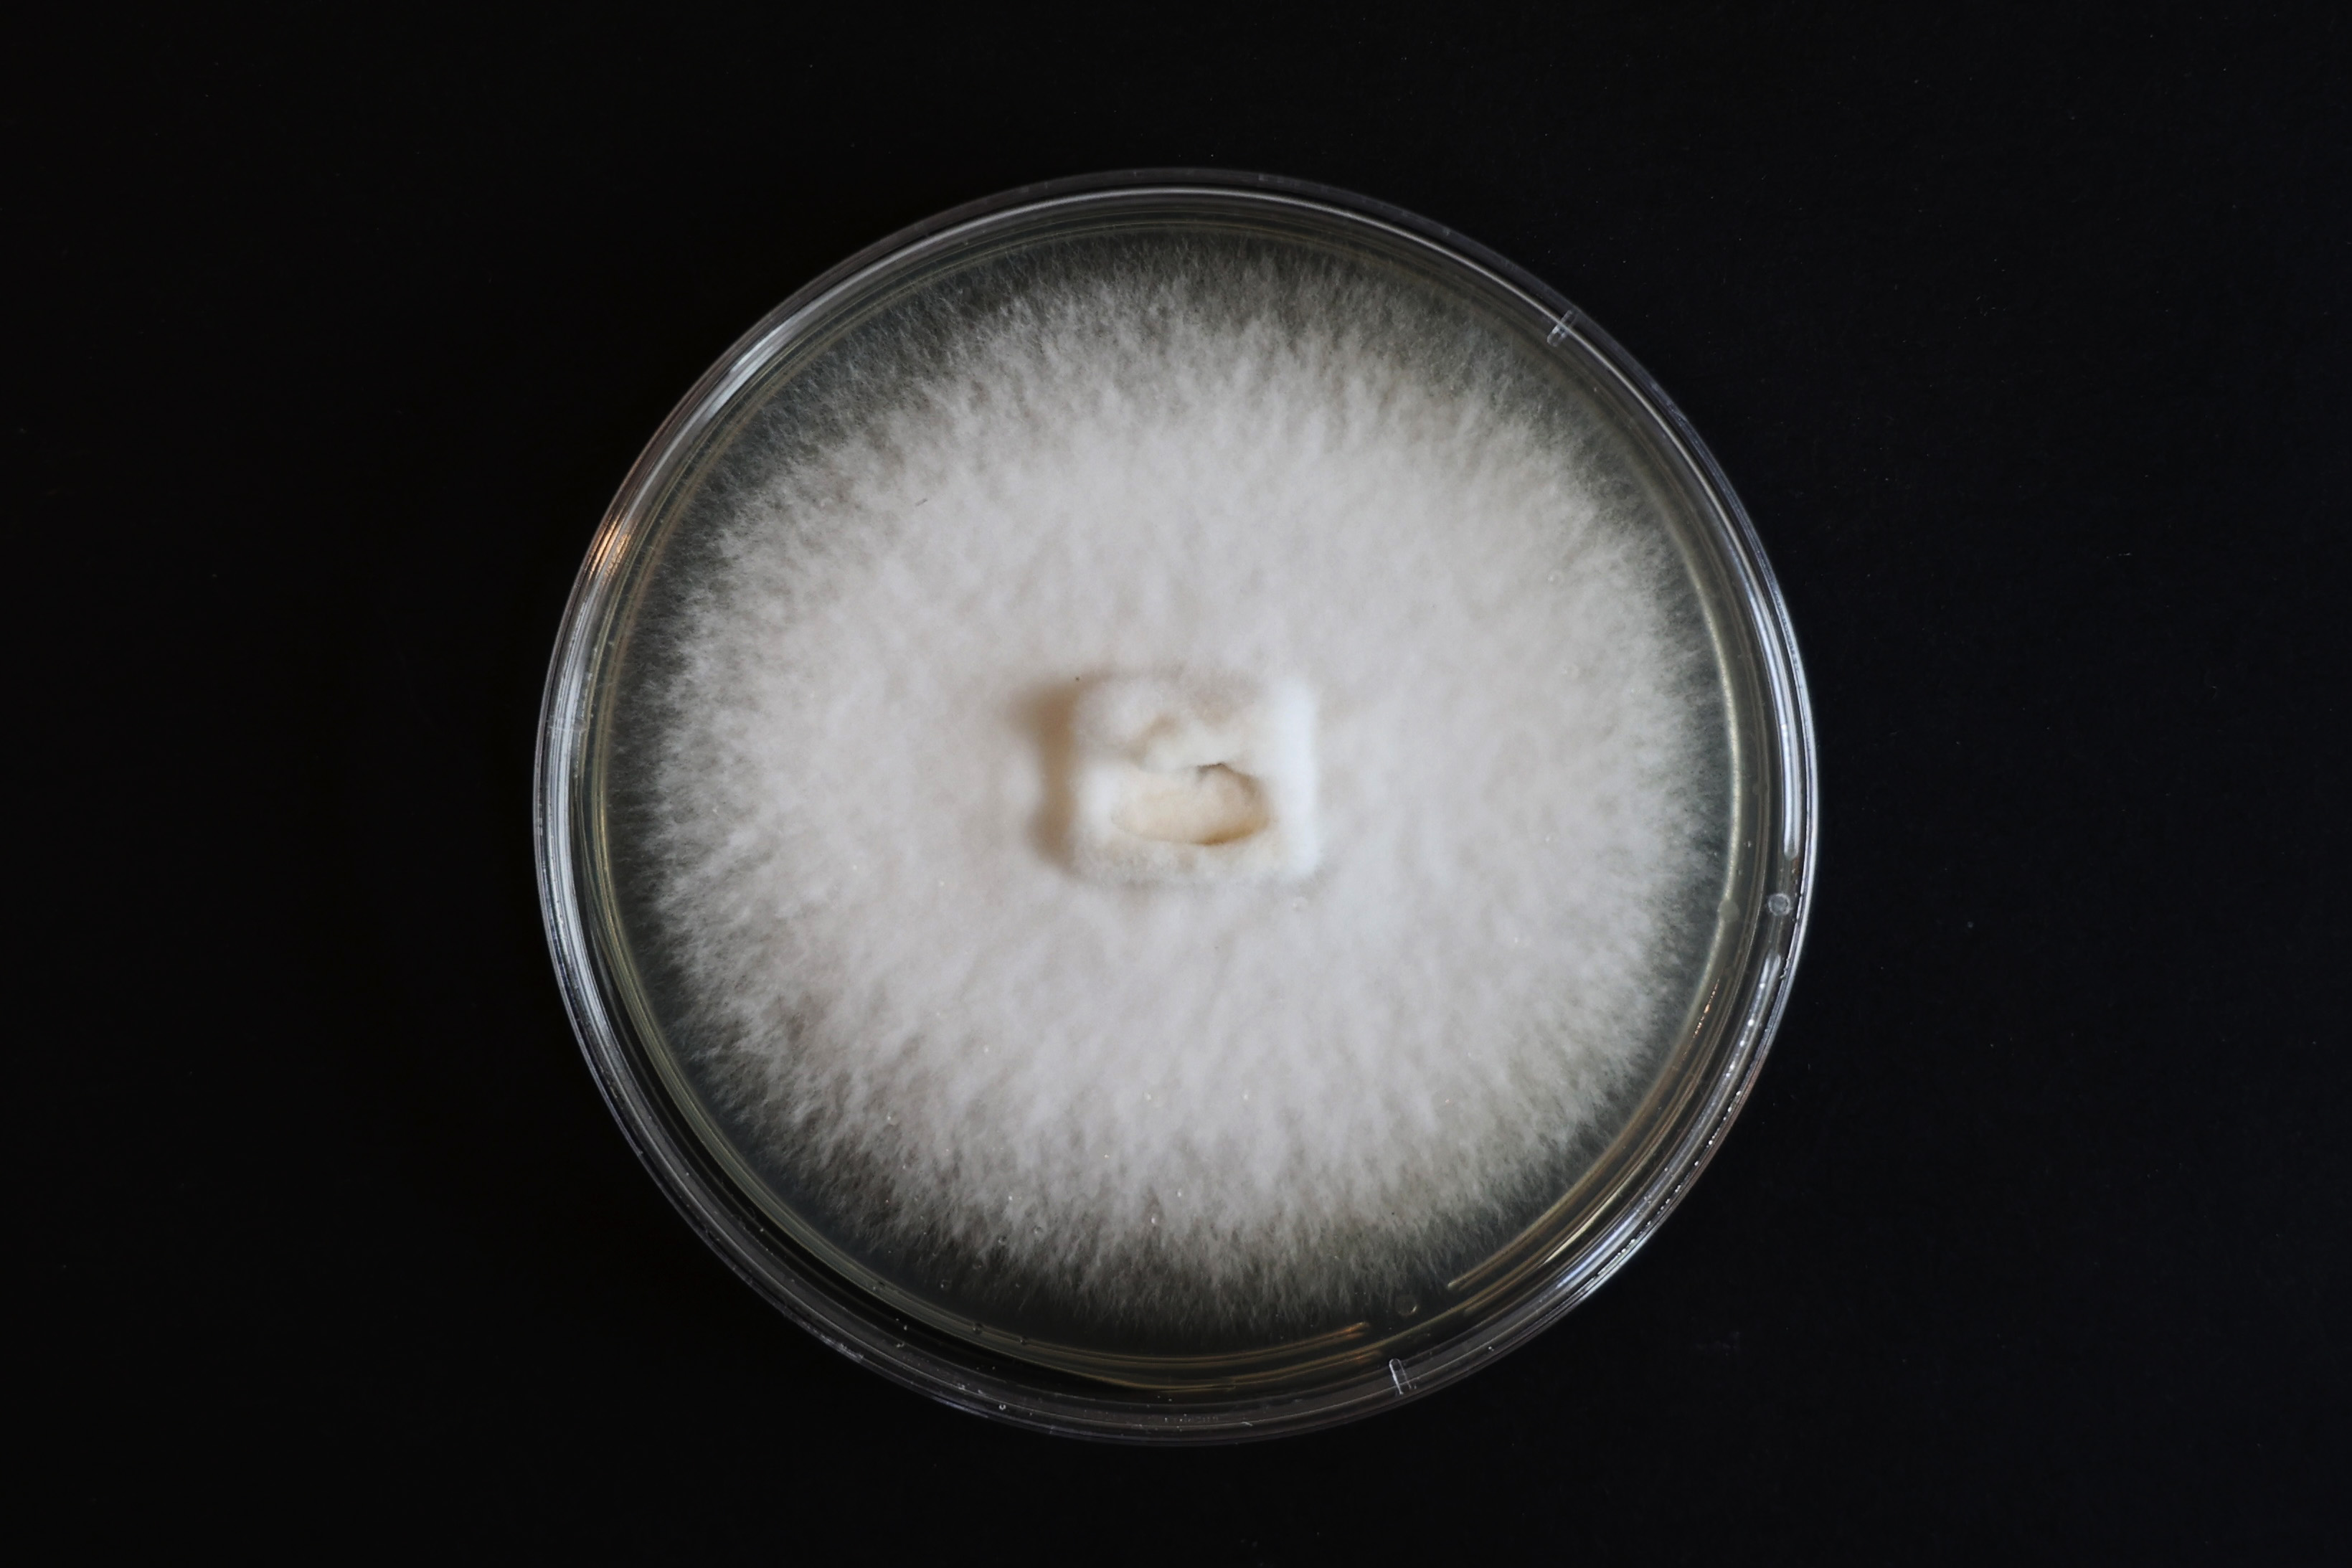
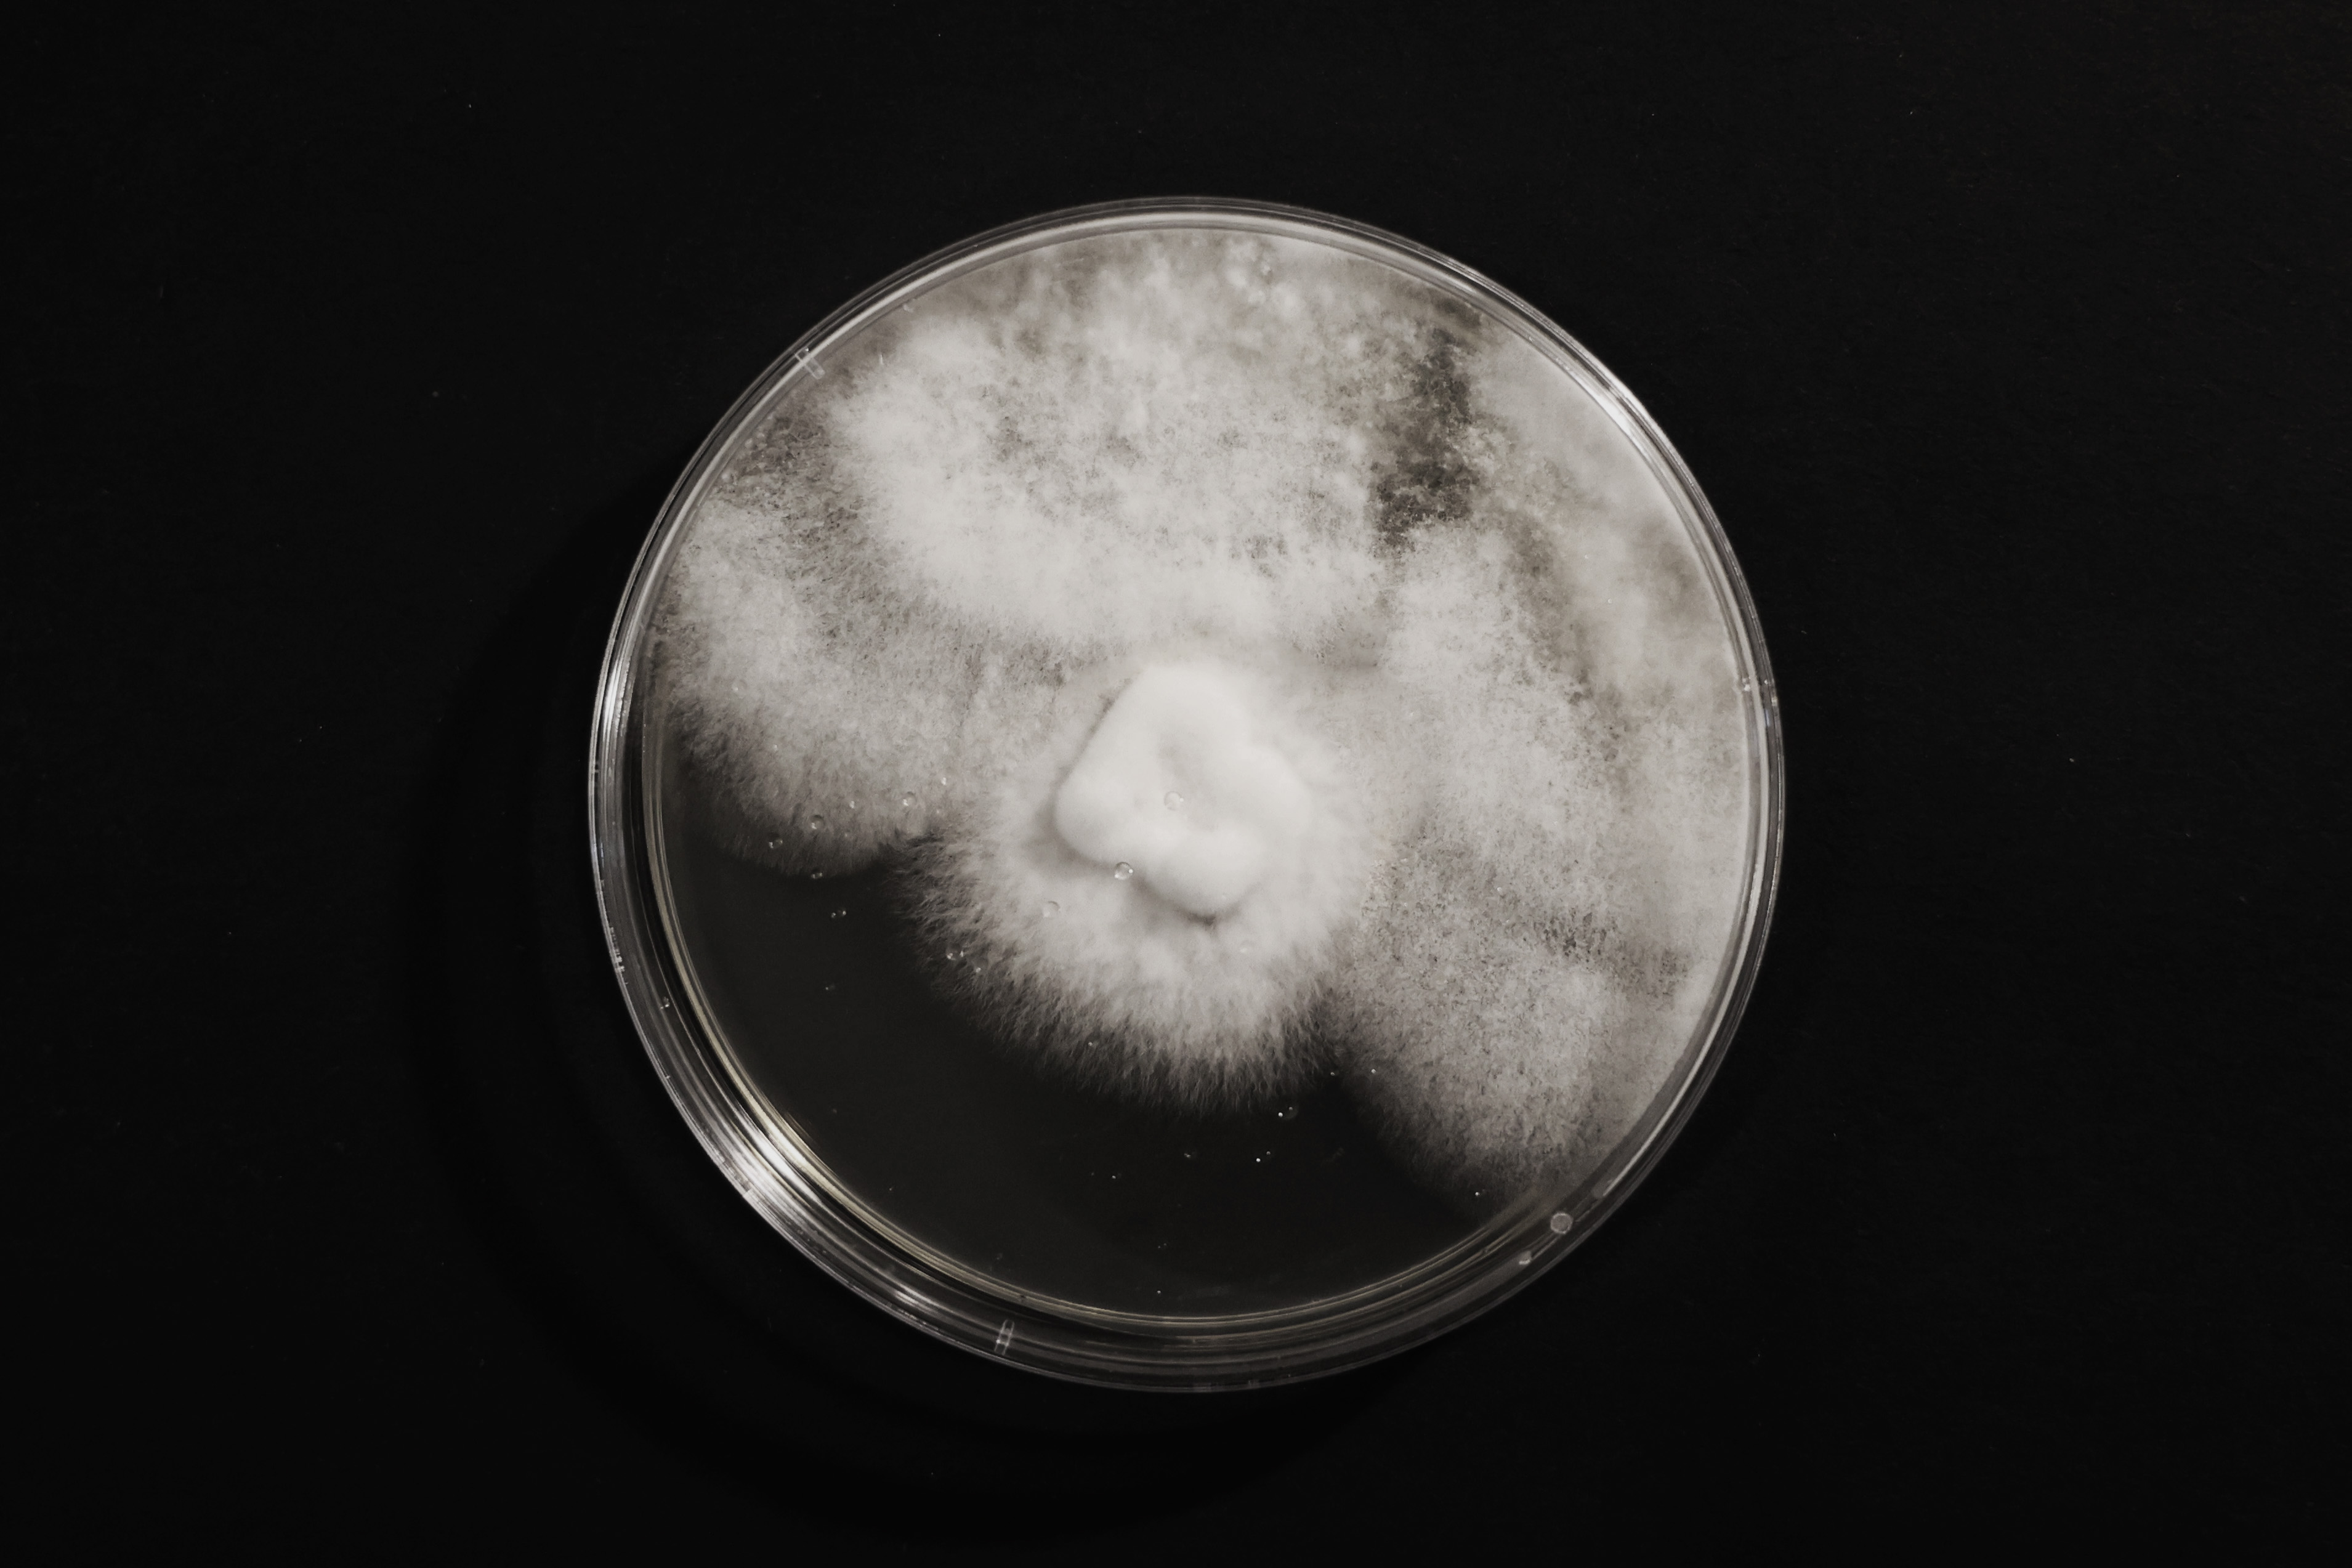

Personal work
Jan2022 - July2022
Keywords
Biodesign, Future material,
Cross-species messaging
Technique
Laser printing, 3D printing, Automation
Jan2022 - July2022
Keywords
Biodesign, Future material,
Cross-species messaging
Technique
Laser printing, 3D printing, Automation
For the past year, I've been focusing on how to break down Information transmission barriers between humans and other species, as well as developing some new tools to serve as a medium through which humans and other species in the biological system can try to communicate and cooperate smoothly.
This project develops a cross-species basic language system for transmitting information to fungi by manipulating the intensity and shape of light. A possibility called nature-assisting human design and construction is proposed to break the inertia of human beings alone in the past.
This project develops a cross-species basic language system for transmitting information to fungi by manipulating the intensity and shape of light. A possibility called nature-assisting human design and construction is proposed to break the inertia of human beings alone in the past.
1. Project Logical Chain
'Mycelian' is a project that develops a cross-species basic language system for Transferring information to fungi by manipulating the intensity and shape of light. A possibility called nature-assisting human design and construction is proposed to break the inertia of human beings alone in the past.

2. Strain Screening
Selecting a fungi species that grows quickly and is easy to cultivate.

Shiitake mushroom
Period:10-14days
Period:10-14days
Mucor
Period: only 1 day
Period: only 1 day
Agaricus bisporus
Period: 15-20days
Period: 15-20days
Shiitake mushroom, oyster mushroom, King oyster mushroom, Agaricus bisporus, and Mucor were selected as potential strains for this experiment from a variety of fungal species. These strains are screened for the second time based on their growth rate, the environment required for growth, and other factors.
Finally, the Mucor with the shortest growth period (1 to 2 days) and the ability to survive at most temperatures and humidity levels was chosen experimentally as the strain for this project.
3.Light Control Experiment (The fungus is continuously exposed to light of various wavelengths)
*The growth of fungi is affected by light: Fungal species have been shown to respond to light qualities ranging from ~450 nm (blue) to ~ 700 nm (red), approximating the span of the human visible spectrum. [1]
*If the power of the light source is above the threshold, the growth direction of the mycelium will not be affected;
Conversely, the fungal growth will be terminated.

︎︎︎
︎︎︎
︎︎︎



Red laser(350nm 50mW):
no effect
no effect
Green laser(520nm 50mW):
weak effect
weak effect
Purple laser(405nm 50mW):
obvious effect
obvious effect
Result:
> The fungus can be well controlled by the laser, and the purple laser of 405nm, 50mw has the best effect. Therefore, purple laser at 405nm, 50mw was chosen as the light source for the subsequent experiments.
4.Fungal 2D Printer design
The light repeatedly irradiates the medium in a continuous back and forth motion according to the set shape. The purpose is to verify that continuous moving light irradiation has the same effect as a continuous direct light source on the fungus.



Continuous point light source forming a straight line
Continuous linear light sources
form the
surface
surface
Multi-point continuous light mode
function
function
------------> ------------>


Fungal 2D Printer demonstration
2D fungal printer running program interface
Moving Light Source Experiment (Using experiment to prove not only fixed light sources, but fungi can also be affected by mobile light sources)
Printing of Mucor was performed for a sustained day using a 2D fungal printer designed and built according to experimental requirements:



0h
12h
24h
Separate experiments were conducted using different kinds of print patterns, ranging from straight lines, straight line combination, curves, rectilinear figure, curvilinear figure, combination of line and surface:

Result: Experiments have demonstrated that mobile light sources can have the same effect on fungi growth as fixed light sources.
5.Fungal 3D Printer Design (Superimposing 2D patterns into 3D models)
Based on the characteristics of fungal light avoidance growth, designed the printer to form a three-dimensional light-free cavity by moving the light source back and forth.
Operation Mechanism


Triangular stop motion mechanism in front of the light source:
Rotation of the servo drives the vertical movement of the triangular light blocker up and down.
Rotation of the servo drives the vertical movement of the triangular light blocker up and down.
The triangular stopper blocks the light in a linear shape,
resulting in a lightless area cavity.
resulting in a lightless area cavity.

Modeling 3D Printer with rhino
Main components & parameters

3D printer component parameters


Servo-driven triangular blocker
Synchronous belt slide
with infeed motor
6.Software Control System
Developing a model generation program based on grasshopper:
The shape of the model to be printed is generated by adjusting the slider in the grasshopper.


Model Generation Demonstration
Model shape controller:
· Slider controller on the three bottom horizontal axes of the printer
· Triangular blocker controller: on the printer's three vertical axes
· Slider controller on the three bottom horizontal axes of the printer
· Triangular blocker controller: on the printer's three vertical axes

Grasshopper program pack for controlling the printer to generate models
︎︎︎

Example of model generation process
Virtual Demonstration

Simulation of the printing process by a fungal 3D printer in grasshopper
7.Light Source Combination
A summary of the 3 categories (9 types) of graphics that can be produced by the printer's light source, based on its range of motion and logic.

8.Hardware Development




Wire schematic: Control 6 stepper motors with 3 servos at the same time by Raspberry Pi pico.
Data output
9.Program Running Demonstration









[1] Fuller, K.K., Loros, J.J. & Dunlap, J.C. Fungal photobiology: visible light as a signal for stress, space and time. Curr Genet 61, 275–288 (2015). https://doi.org/10.1007/s00294-014-0451-0
︎︎︎BACK NEXT︎︎︎